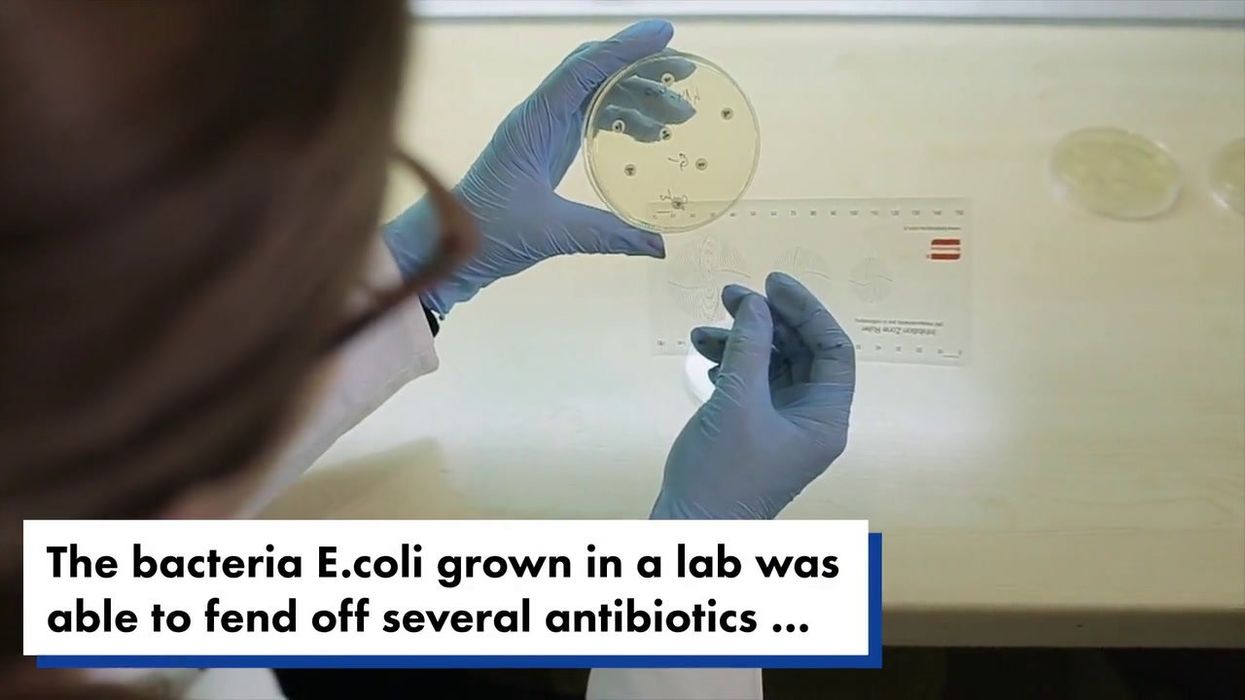
Triathlon ends in chaos after 57 swimmers fall ill with diarrhoea

A triathlon ended on a bum note after at least 57 people fell ill with sickness and diarrhoea after the competition.
About 2,000 people participated in events in the World Triathlon Championship Series in Sunderland, and some who swam fell ill, health officials confirmed this weekend.
The UK Health Security Agency (UKHSA) said it would be testing samples from those who were ill to establish the cause of the illness and any common pathogens.
An Environment Agency sampling at Roker beach, where the athletes swam, on Wednesday 26 July, three days before the event, showed 3,900 E Coli colonies per 100ml, more than 39 times higher than typical readings the previous month. E coli is a bacterial infection which can cause stomach pain and bloody diarrhoea,
But British Triathlon, the governing body for triathlons in Great Britain, said the agency’s sampling results were not published until after the weekend’s events and were outside the body of the water where its competitions took place. It said its own testing results passed the required standards for the event.
Sign up to our free Indy100 weekly newsletter
Jacob Birtwhistle, 28, an Australian triathlete, posted the Environment Agency’s results on Instagram and said he had felt unwell after the event. He wrote: “Have been feeling pretty rubbish since the race, but I guess that’s what happens when you swim in shit. The swim should have been cancelled.”
And people on social media thought it was revolting:
The UKHSA said: “UKHSA is working with British Triathlon to encourage anyone who participated and has or had symptoms after the event to contact the organisers who will then pass details onto the UKHSA North East Protection team. The team will undertake an investigation of cases.”
A spokesperson for Northumbrian Water said: “We have had no discharges from any of our assets that might negatively impact water quality at either Roker or the neighbouring Whitburn North bathing water since October 2021.
“Both bathing waters were designated as ‘Excellent’ in the latest Defra classifications, and sampling to date in the current season indicate this high quality is being maintained.”
What a s**t situation.
Have your say in our news democracy. Click the upvote icon at the top of the page to help raise this article through the indy100 rankings.